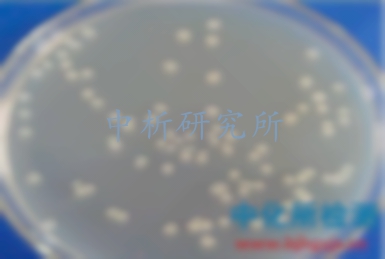
枯草芽孢桿菌檢測

枯草芽孢桿菌檢測,枯草芽孢桿菌檢測機構,枯草芽孢桿菌第三方檢測
1對1客服專屬服務,免費制定檢測方案,15分鐘極速響應
發布時間:2025-07-25 08:49:03 更新時間:2025-09-14 14:34:57
點擊:403
作者:中科光析科學技術研究所檢測中心
1對1客服專屬服務,免費制定檢測方案,15分鐘極速響應
發布時間:2025-07-25 08:49:03 更新時間:2025-09-14 14:34:57
點擊:403
作者:中科光析科學技術研究所檢測中心
中科光析科學技術研究所微生物檢測中心可對枯草芽孢桿菌進行檢測,包括飼料,飼用微生物制劑,枯草芽孢桿菌菌粉,枯草芽孢桿菌發酵液。有機肥等,國內第三方枯草芽孢桿菌檢測機構,檢測項目包括耗氧量,定量檢測,含量檢測,活菌數含量等, 中析研究所枯草芽孢桿菌檢測周期短,費用低,可出具范圍認可的枯草芽孢桿菌檢測報告。
檢測范圍:飼料,飼用微生物制劑,枯草芽孢桿菌菌粉,枯草芽孢桿菌發酵液。有機肥,枯草芽孢桿菌培養基,納豆枯草芽孢桿菌等。
檢測項目:耗氧量,定量檢測,含量檢測,活菌數含量,成分檢測等。
檢測標準:
121CFR 173.115-2013由重組枯草芽孢桿菌提取的α-乙酰乳酸脫羧酶([α]-α-ALDC)酶制劑
2GB/T 26428-2010飼用微生物制劑中枯草芽孢桿菌的檢測
3NY/T 2131-2012飼料添加劑 枯草芽孢桿菌
4NY/T 2293.1-2012細菌微生物農藥 枯草芽孢桿菌 第1部分:枯草芽孢桿菌母藥
5NY/T 2293.2-2012細菌微生物農藥 枯草芽孢桿菌 第2部分:枯草芽孢桿菌可濕性粉劑
為什么選擇中科光析科學技術研究所做枯草芽孢桿菌檢測?
1、中析研究所枯草芽孢桿菌檢測中心資質齊全,資質認證的第三方檢測機構。
2、數據準確,博士團隊,歐美進口檢測設備,保證了數據的準確性。
3、研究所檢測報告支持二維碼查詢真偽。
4,多家分支機構,支持上門取樣,免費初檢。
5,售后服務,相關工程師一對一服務。
6,可出具中英文檢測報告。
枯草芽孢桿菌檢測流程
1、電話咨詢
2、郵寄枯草芽孢桿菌樣品或上門取樣。
3、工程師報價
4、支付檢測費用,開展實驗。
5、完成實驗,出具檢測報告。
6、郵寄檢測報告,售后服務。
證書編號:241520345370
證書編號:CNAS L22006
證書編號:ISO9001-2024001

版權所有:北京中科光析科學技術研究所京ICP備15067471號-33免責聲明